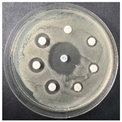
Pharmaceutics 16 00716 i002
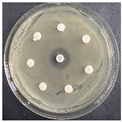
Pharmaceutics 16 00716 i003
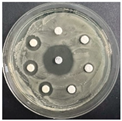
Pharmaceutics 16 00716 i007
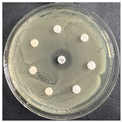
Pharmaceutics 16 00716 i008
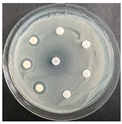
Pharmaceutics 16 00716 i010
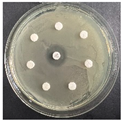
Pharmaceutics 16 00716 i018
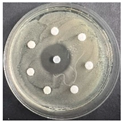
Pharmaceutics 16 00716 i027

Abstract
(1) Background: Antimicrobial resistance is growing at an extreme pace and has proven to be an urgent topic, for research into alternative treatments. Such a prospective possibility is hidden in antimicrobial peptides because of their low to no toxicity, effectiveness at low concentrations, and most importantly their ability to be used for multiple treatments. This work was focused on the study of the effect of the modification in position 7 of Temporin A on its biological activity; (2) Methods: The targeted peptides were synthesized using Fmoc/Ot-Bu SPPS. The antibacterial activity of the analogs was determined using the broth microdilution method and disk-diffusion method. In vitro tests were performed to determine the cytotoxicity, phototoxicity, and antiproliferative activity of the peptide analogs on a panel of tumor and normal cell lines; (3) Results: All analogs except DTCit showed good antibacterial activity, with DTDab having the best activity according to the disk-diffusion method. However, DTCit had an acceptable cytotoxicity, combined with good selectivity against the test MCF-7 cell line; (4) Conclusions: The obtained results revealed the importance of the basicity and length of the side chain at position 7 in the Temporin A sequence for both tested activities.
1. Introduction
The natural mechanisms of microorganisms to ensure their survival in their environment includes the secretion of specific substances able to kill other bacteria and allow the proliferation of the strain. At the same time, these substances must be non-toxic against their strain producer [1]. Most of the antibiotics currently used in medicinal practice are naturally secreted by bacteria or fungi, in order to ensure the process of their survival.
Resistance against the used antimicrobial substances is one of the most prevalent global health threats. The World Health Organization (WHO) stated that a time with untreatable infections with current antibiotics is forthcoming [2]. According to the “Global burden of bacterial antimicrobial resistance” report for 2019, antimicrobial resistance (AMR) was unequivocally accountable for 1.27 million deaths worldwide and indirectly for another 4.95 million. In addition, AMR might surpass cancer mortality in less than 30 years and by 2050 claim 10 million lives annually [3].
Antimicrobial peptides (AMPs) have become a promising alternative as broad-spectrum antimicrobial agents [4]. In 1957, for the first time, Robert Skarnes discovered antimicrobial peptides in blood cells. Since then, over 1200 AMPs have been isolated from diverse sources, such as bacteria, plants, insects, and animals [1]. In contrast to conventional antibiotics, AMPs realize contact with the cell membranes by neutralizing the charge, then pass through the membranes to destroy the bacteria and lessen the likelihood that they will develop drug resistance. In addition, they are also effective at low concentrations and on certain types of bacteria that are resistant to common antibiotics such as vancomycin-resistant Enterococcus and methicillin-resistant Staphylococcus aureus. Furthermore, AMPs can be applied in combination with conventional antibiotics in search of a synergistic effect. Moreover, they are considered safe for use, with less or lack of side effects, and are unlikely to cause drug resistance. As an added benefit, they possess a broad spectrum of antimicrobial properties compared to traditional antibiotics [5,6,7]. Natural peptides have multifunctional activity, i.e., they are able to target several points of interest [1,6]. Most AMPs are cationic, amphiphilic, generally positively charged, and they range from 10 to 60 amino acid residues, with an overall charge of +2 to +9. In addition, they are characterized by the presence of positively charged basic amino acids like lysine and arginine, as well as hydrophobic residues [5,6,8].
Although it is challenging to classify natural AMPs, due to their diversity, they can be categorized in several ways:
- According to their origin, AMPs are divided into four groups—mammalian, amphibian, microorganism-derived, and insect-derived. Representatives of the first group include defensins, cathelicidins, and lactoferricin B. A significant part of the amphibian defense against pathogens is provided by own-produced AMPs [9]. The well-known first group magainins are isolated from frogs [10]. Microorganisms such as bacteria and fungi can also yield antimicrobial peptides. Notable examples of such peptides include nisin and gramicidin, which are synthesized by Bacillus subtilis, Lactococcus lactis, and Bacillus brevis strains. The strong ability of insects to adapt is largely due to AMPs, which are primarily synthesized in their blood cells and fat bodies. Found in bees, guppy silkworms, and Drosophila, cecropins are the most well-known family of AMPs found in insects [8,11];
- According to their activity—an overview of the activities of AMPs includes peptides with antibacterial, antifungal, antiviral, antiparasitic, and antitumor activities. Antibacterial peptides are a significant part of AMPs and have a comprehensive inhibitory activity against many pathogenic bacteria. Many AMPs such as nisin, defensins, and cecropins have demonstrated good inhibition of Gram-positive and Gram-negative bacteria. Antifungal peptides, a subclass of AMPs, target fungal infections with an increased resistance to drugs. Examples of such peptides include brevinine, cecropin, and ranatuerin. Antiviral peptides are also an important class of AMPs that show a potent killing effect on viruses. Antiparasitic peptides have the ability to eradicate parasites responsible for diseases like malaria and leishmaniasis. Anticancer peptides demonstrate their antiproliferative effects by enlisting immune cells to destroy tumor cells. Thus, cancer cells necrotize or undergo apoptosis. In addition, anticancer peptides block angiogenesis to stop tumor growth as well as metastasis, and lastly activate specific regulatory functional proteins to obstruct tumor cell gene transcription and translation [6,8];
- Based on their structures—there are four groups of AMPs: β-sheet peptides, linear α-helix peptides, and peptides, with and without both structural elements. Hundreds of distinct sequences of the α-helix conformational peptides have already been identified from natural sources. Thus, they represent a relatively diverse and extensively researched class of AMPs. There are many different data in the scientific literature concerning the chain length of the AMPs, but most often they contain 12–40 amino acids, with a high concentration of helix-stabilizing residues like Ala, Lys, and Leu. Every β-family of AMPs possesses a minimum of one pair of two β-strands. Nearly all the AMPs in this group have cysteine residues, which can form one or more disulfide bridges that stabilize their structures. These peptides exhibit greater stability in solution and do not significantly alter the structural makeup of the membrane environment. AMPs with both α-helix and β-sheet elements have been reported in a variety of invertebrates and plants, in addition to humans and other mammals. These AMPs are categorized according to the various configurations of their three to five disulfide bonds. Some AMPs are known as extended linear structures, because they do not take on a particular 3D structure in solution or when they come into contact with membranes. These peptides are typically enriched amino acids, such as Gly, Pro, Trp, or His, and lack α-helices and β-sheets [8,11].
AMPs achieve their antimicrobial effects using two main mechanisms. The membrane-targeting AMPs damage the structure of the cell membrane, whereas the non-membrane-targeting AMPs stop the synthesis of nucleic acids, crucial enzymes, and functional proteins [2,8].
Net charge, amphipathicity, hydrophobicity, membrane curvature, and propensity for self-aggregation are among the physicochemical characteristics of AMPs that play a crucial role in the peptide–membrane interactions that lead to the disruption of membrane integrity. Hydrophobic and cationic interactions are the main types of action of membrane-active AMPs. Initial binding of the positively charged residues of AMPs to the negatively charged bacterial cell surface is realized by electrostatic attraction. Some specific peptide–peptide or lipid–peptide complex structures are formed when the concentration of AMPs adhered to the membrane rises. Once the concentration of AMPs on the membrane has reached a critical level, they enter the core of hydrophobic bilayers and create transmembrane pores within the cytoplasmic membrane. According to the barrel-stave model, AMP molecules self-assemble when they adsorb on the membrane surface through interactions with hydrophilic peptide regions. The peptide bulks rotate perpendicularly to the plasma membrane when the accumulated peptide monomers reach a specific density on the membrane. Lastly, the hydrophilic surface of the channel is directed inward as the peptide bulks form a channel along the hydrophobic portion of the bilayer. The mechanism of action of the toroidal model states that, in contrast to the barrel-stave model, peptides are introduced perpendicularly into the bilayer, to form a peptide–lipid complex rather than peptide–peptide interactions. A “toroidal pore” is formed as a result of the peptide conformation, which encourages a specific membrane curvature that is partially surrounded by phospholipid head groups and partially by peptides. Due to an interaction between the negatively charged polar phospholipid heads and the positively charged cationic peptides, AMPs adhere parallel to the membrane surface in the carpet model. The peptides accumulate to reach a critical concentration, and then reverse their orientation to form micelles with a hydrophobic core within the membranes, which results in membrane dissolution [2,5].
Short, homologous AMPs called temporins were extracted from the skin of frogs belonging to the Rana genus by Simmaco et al. [12]. Temporins were labelled as ‘‘Vespa-like’’ due to their structural similarity to the short peptides found in the venom of wasps from the genus Vespa. Temporins and Vespa peptides share certain characteristics, such as hydrophobicity, a low molecular weight, and antimicrobial activity. Leu is the most prevalent amino acid in the sequence of temporins, with hydrophobic residues making up 70% of the peptide [13]. Temporins are the largest group of AMPs found in amphibians. A single specimen can contain up to 10 different isoforms [14]. The most researched peptides of the group as antimicrobials are Temporin A (FLPLIGRVLSGIL-NH2, herein abbreviated with DTA), Temporin B (LLPIVGNLLKSLL-NH2), Temporin F (FLPLIGKVLSGIL-NH2, herein abbreviated with DTF), and Temporin L (FVQWFSKFLGRIL-NH2). Their amino acid sequences are primarily made up of hydrophobic residues, and they are C-terminally α-amidated [13]. Most of them are non-toxic to human red blood cells at doses able to kill bacteria [15]. With a net charge of 0 to +3, their activity is especially vectorized to Gram-positive bacteria. This family contains one notable exception, Temporin L, which is extremely effective against both Gram-positive and Gram-negative strains. They are amphipathic α-helical AMPs, to date discovered in nature with a length of 10 to 14 amino acids, making them among the smallest AMPs. Although membrane penetration is not inherently fatal, their mode of action entails changing the permeability of the microbial membrane, which permits both small and large molecules to flow through [14]. The antibacterial activity of Temporin A was found to be significantly influenced by the presence of a hydrophobic residue at the N-terminus and the bulky ones at positions 5 and 12. With mild hemolytic activity, Temporin A is mostly active against Gram-positive bacteria [13]. According to Wade et al., who first reported synthesis of Temporin F, a minor change in position 7 by replacement of a strongly basic Arg residue by less basic Lys residue leads to decreasing the antibacterial activity [15]. Thus, in this study, we continued the work started by Wade et al. to explore the influence of the basicity of the amino acid in the position 7 of the Temporin A molecule on the antibacterial activity, introducing in this position the unnatural amino acids ornithine (Orn), citrulline (Cit), 2,4-diaminobutyric acid (Dab), and 2,3-diaminopropionic acid (Dap). Taking into account that AMPs often have additional antiproliferative activity, due to similar mechanisms of penetration in the cell membrane, we also investigated the phototoxicity, cytotoxicity, and antiproliferative effect of the newly synthesized peptides and compared their activities to those of the parent peptide [16,17].
2. Materials and Methods
2.1. Synthesis and Analytical Data
The specifically protected amino acids needed for targeted peptide synthesis Fmoc-L-Leu-OH, Fmoc-L-Phe-OH, Fmoc-L-Val-OH, Fmoc-L-Pro-OH, Fmoc-Gly-OH, Fmoc-L-Arg(Pbf)-OH, Fmoc-L-Ile-OH, Fmoc-L-Lys(Boc)-OH, Fmoc-L-Ser(Trt)-OH, Fmoc-L-Cit-OH, Fmoc-L-Orn(Boc)-OH, Fmoc-L-Dab(Boc)-OH, Fmoc-L-Dap(Boc)-OH as well as polymer carrier Fmoc-Rink-Amid-MBHA Resin, activation agents N,N′-Diisopropylcarbodiimide (DIC), N,N,N′,N′-Tetramethyl-O-(1H-benzotriazol-1-yl)uronium hexafluorophosphate (HBTU), 2-(1H-Benzotriazole-1-yl)-1,1,3,3-tetramethylaminium tetrafluoroborate (TBTU), N-Hydroxysuccinimide (HOSu), Benzotriazol-1-yloxy)tripyrrolidinophosphonium hexafluorophosphate (PyBOP), scavenger triisopropylsilane (TIS), base N,N-diisopropylethylamine (DIPEA), and trifluoroacetic acid (TFA) were purchased from Iris Biotech GmbH (Marktredwitz, Germany). The solvents for the synthesis N,N′-dimethylformamide (DMF) and dichloromethane (DCM) were purchased from Valerus Ltd. (Bulgaria). All reagents and solvents were applied without any pretreatment.
For the synthesis of the desired compounds, the established solid-phase peptide synthesis Fmoc(9-fluorenylmethoxycarbonyl)/Ot-Bu strategy on Rink-amide MBHA resin was employed. The amino acids were activated using DIC, HBTU, TBTU, or PyBOP. The coupling reactions were carried out using amino acid/HBTU(or PyBOP or TBTU)/DIPEA/resin at a molar ratio 3/3/3/9/1 or amino acid/DIC/1-HOSu/resin at a molar ratio 3/3/3/1. The deprotection of the Fmoc-group was achieved with a 20% piperidine/DMF solution. The Kaiser test was utilized to monitor both coupling and deprotection reactions. A cocktail of 95% trifluoroacetic acid (TFA), 2.5% triisopropylsilane (TIS), and 2.5% distilled water was used to cleave the final peptides from the resin. Each peptide was extracted as a filtrate in TFA and then precipitated using cold, dry diethyl ether. HPLC-MS/MS analyses were performed after the precipitate had been filtered.
The peptide purity was controlled on a RP-HPLC Agilent Poroshell 120, 100 mm × 4.6 mm column using a Shimadzu LC MS/MS 8045 system, flow rate of 0.30 mL/min, column temperature of 40 °C, and a linear binary gradient, consisting of Mobile phase A: H2O (10% Acetonitrile (AcCN); 0.1% HCOOH) and Mobile phase B: AcCN (5% H2O; 0.1% HCOOH) with the following scheme over time:
| Time (min) | Mobile phase A (%) | Mobile phase B (%) |
| 0.01 | 80 | 20 |
| 10.00 | 5 | 95 |
| 15.00 | 5 | 95 |
| 15.50 | 80 | 20 |
| 22.00 | 80 | 20 |
The structures of the newly synthesized compounds were established by electrospray ionization mass spectrometry in the SCAN regime/ESI+ mode of ionization, with the following parameters:
| Nebulizing gas flow | 3 L/min |
| Heating gas flow | 10 L/min |
| Interface temperature | 350 °C |
| DL temperature | 200 °C |
| Heat block temperature | 400 °C |
| Drying gas flow | 10 L/min |
An automated standard polarimeter PolamatA (Carl Zeis, Jena; Anton Paar Opto Tec GmbH, Seelze, Germany) was used to determine optical rotation at c = 1 (MeOH). Melting temperatures were measured using an A. KRÜSS Optronic GmbH semi-automatic melting pointmeter (M3000). Table 1 summarizes all obtained analytical data.
Table 1.
Structure and analytical data for newly synthesized compounds.
2.2. Cell Cultures
The cell lines BALB 3T3 (mouse embryonic fibroblasts) and MCF-12F (human breast epithelial cells) were used as models for healthy tissue. The MCF-7 and MDA-MB-231 cell lines were used as in vitro models for luminal A- and basal B-type breast cancer, respectively. Cell lines were obtained from the American Type Cultures Collection (ATCC, Manassas, VA, USA). Cells were cultured in Dulbecco modified Eagle’s medium (DMEM) supplemented with 10% fetal bovine serum (FBS), 100 U/mL penicillin, and 0.1 mg/mL streptomycin (Sigma-Aldrich, Schnelldorf, Germany) in an incubator at 37 °C, 5% CO2 and 95% humidity. Plastic flasks 75 cm2 (Biologix, Lenexa, KS, USA) were used to grow the cells.
2.2.1. In Vitro Cytotoxicity Testing (3T3 NRU Test)
The cytotoxicity/phototoxicity testing was performed as described by the OECD Guidelines for the Testing of Chemicals, Section 4, Test No. 432: In Vitro 3T3 NRU Phototoxicity Test. BALB 3T3, clone A31 cells were grown in 75 cm2 tissue culture flasks in DMEM high-glucose (4.5 g/L), 10% FBS, and antibiotics at 37.5 °C, in a humidified atmosphere under 5% CO2. Cells were plated at 1 × 104 cells / 100 μL culture medium in each well of 96-well microplates and allowed to adhere for 24 h before treatment with test compounds. Peptides were dissolved in DMSO and diluted with culture medium to working concentrations from 4 to 1000 μM. In phototoxicity tests, 96-well plates were irradiated (+Irr) with a dose of 2.4 J/cm2 using an artificial solar light simulator Helios-iO (SERIC Ltd., Tokyo, Japan), and the cells were incubated for an additional 24 h. After treatment with a Neutral Red medium, washing, and application of the NR Desorb solution, the absorption was measured on a microplate reader at a wavelength of 540 nm. Cytotoxicity/phototoxicity was expressed as CC50 values (concentrations required for 50% cytotoxicity).
2.2.2. In Vitro Antiproliferative Activity
The antiproliferative activity testing was performed on cell cultures using the MTT-dye reduction assay [18]. This assay is based on the metabolism of MTT to insoluble formazan by mitochondrial reductases. The formazan concentration can be determined spectrophotometrically. The measured absorption is an indicator of cell viability. Cell lines (MCF-12F, MCF-7 and MDA-MB-231) were used in the experiments. Cells were plated at a density of 1 × 103 cells/100 µL in each well of 96-well microplates and allowed to adhere for 24 h before treatment with test compounds. A concentration range from 4 to 1000 μM was applied for 72 h. The formazan absorption was registered using a microplate reader at λ = 540 nm. Antiproliferative activities were expressed as IC50 values (concentrations required for 50% inhibition of cell growth).
The statistical analysis included the application of one-way ANOVA followed by Bonferroni’s post hoc test. This test was used to compare the results (IC50 values) obtained for all tested peptides and to determine statistically significant differences. p < 0.05 was accepted as the lowest level of statistical significance. All results are presented as the mean ± SD.
2.3. Antimicrobial Assay
2.3.1. Strains, Media, and Culture Conditions
The parent peptide Temporin A and the novel analogs were subjected to tests against model strains Escherichia coli NBIMCC 8785, Bacillus subtilis NBIMCC 3562, Arthrobacter oxydans NBIMCC 9333, Pseudomonas aeruginosa NBIMCC 3700, and Candida albicans NBIMCC 74, for the assessment of their antimicrobial activity. The strains were acquired from the National Bank for Industrial Microorganisms and Cell Cultures (NBIMCC, Bulgaria). The strain E. coli 8785 was cultured in Luria-Bertani broth (LB, HiMedia, Mumbai, India); B. subtilis 3562—in nutrient broth (NB, HiMedia, Mumbai, India); A. oxydans 9333; P. aeruginosa 3700—in meat peptone agar (MPA) medium; and C. albicans 74—in yeast mold (YM) medium. An incubator shaker ES-20/60 (Biosan, Latvia) was used for the cultivation and was set to 30 °C for B. subtilis 3562, A. oxydans 9333, and C. albicans 74; and 37 °C for E. coli 8785 and P. aeruginosa 3700, with a 24 h shaking period at 120 rpm. The microbial cultures were then adjusted to a turbidity of 0.5 McFarland using a Grant-bio DEN-1B densitometer (Grant Instruments, Royston, UK) for further use.
2.3.2. Disk-Diffusion Method
The disk-diffusion method was used as an additional method, with the aim of determining the percent inhibition of the tested samples against the model strains. Sterile plates with LB/NB/MPA/YM agar medium were inoculated on the surface with 100 μL from each microbial culture and incubated at 30 or 37 °C for 30 min, for the suspension to penetrate the agar. After that, sterile paper discs (HiMedia, Mumbai, India) with a diameter of 6 mm were soaked with 20 µL of the peptide solutions with concentrations of 1.4 mg/mL and 10 mg/mL and placed on the agar surface. Sterile paper discs with 10% EtOH/H2O were used as a negative control, and the corresponding strain antibiotic disks (HiMedia, Mumbai, India)—as a positive control. The incubation of the plate was performed at 30/37 °C for 24 h. The antimicrobial activity was analyzed by measuring the diameter of the inhibition zones in mm. The experiments were conducted in triplicates, and the average values for the percent of inhibition as a correlation between the inhibition zone of the peptides over the inhibition zone of the antibiotic multiplied by 100 were calculated.
2.3.3. Determination of Minimal Inhibitory Concentration
The minimal inhibitory concentration (MIC) of the peptides was determined using the broth dilution method. Stock solutions of the peptides with a concentration of 10 mg/mL in 10% EtOH/H2O were prepared. Suspensions of the bacteria in the corresponding media were added to 96-well U-shaped bottom polystyrene plates (Deltalab S.L., Spain) and exposed to the peptide in the concentration range from 0 to 320 µg/mL, and a 10% EtOH/H2O control, diluted using the same scheme as the peptides, was also used. The plates were then incubated under aerobic conditions at the corresponding temperature for 24 h. The MIC (µg/mL) was assumed as the lowest concentration of the antimicrobial, where there was visible inhibition of the strain. The absorbance was measured at 630 nm (Microplate reader PKL PPC 142, Paramedical srl, Salerno, Italy). To determine the minimal bactericidal concentration (MBC) and minimal fungicidal concentration (MFC), 10 μL from concentrations greater than or equal to the MIC was placed on the corresponding solid nutrient medium. The Petri dishes were then incubated at 30 or 37 °C for 24 h. All experiments were conducted in a triplicate.
3. Results
3.1. Peptide Synthesis and Characterization
Temporin A, Temporin F, and novel C-terminal amidated analogs with a general structure FLPLIG-X-VLSGIL-NH2, where X represents Arg, Lys, Cit, Orn, Dab, and Dap, were synthesized (Figure 1).
Figure 1.
Structures of the moderated amino acids in the position 7 of Temporin A.
All peptides were obtained by a SPPS, Fmoc/Ot-Bu strategy following the cycle presented in Figure 2. The physicochemical characteristics of the newly synthesized molecules are presented in Table 1.
Figure 2.
General procedure for solid-phase peptide synthesis (SPPS).
3.2. Safety Testing
The peptides were studied for safety using an in vitro 3T3 NRU test. The cytotoxicity/phototoxicity expressed in % relative to the negative control was determined. Dose–response dependence was observed for all peptide analogs (Figure 3). At a concentration of 60 µg/mL, no cytotoxic effect was observed on the test peptides. CC50 values (50% cytotoxic concentration) were calculated through nonlinear regression analysis (Table 2). The peptide analogs tested had significantly lower toxicity (p < 0.001) than the natural peptide Temporin A. The exception was DTF, where increased toxicity (CC50 = 92.40 ± 2.82 µM) was observed. To evaluate the phototoxic potential of the investigated peptide analogs, we used the photo irritation factor (PIF), which was calculated using the following formula: PIF = CC50 − Irr/CC50 + Irr. The PIF showed us the probability that the test peptide may cause a phototoxic effect (PIF < 2 = not phototoxic, 2 ≤ PIF < 5 = probable phototoxicity, PIF ≥ 5 = phototoxic). For all tested peptides, the calculated PIF was <2, which shows a high level of photo safety.

Figure 3.
Dose–response curves for cyto- and phototoxicity of peptide analogs determined in BALB 3T3 clone A31 cell line. Values are means ± SD, n = 6.
Table 2.
Cytotoxicity/phototoxicity in BALB 3T3 clone A31 cell line, mean CC50 values and PIF factor.
3.3. In Vitro Antiproliferative Activity
The peptides were studied for their antiproliferative activity with a MTT dye-reduction assay. Cells were incubated with the test peptides at a concentration from 4 to 1000 µM under standard cell culture conditions. The antiproliferative activity expressed in % relative to the negative control was determined. The obtained results are shown in Figure 4 and Figure 5. The mean IC50 values and selectivity index were calculated and are presented in Table 3.
Figure 4.
Antiproliferative activity of peptide analogs in the non-tumorigenic cell line MCF-12F (healthy tissue model). Values are means ± SD, n = 6.
Figure 5.
Antiproliferative activity of peptides determined in tumor cell lines (a) MCF-7 and (b) MDA-MB-231 (in vitro model of breast cancer). Values are means ± SD, n = 6.
Table 3.
Average IC50 values and selectivity index.
3.4. Antimicrobial Activity
3.4.1. Disk-Diffusion Method
The disk-diffusion method was used as a preliminary method, in order to determine the susceptibility of the testing strains towards the parent peptides DTA and DTF, as well as the newly synthesized analogs. For the purpose of this investigation, the microbial cultures were placed on sterile medium plates over a thin layer (100 μL). On paper sterile discs, 20 μL of 1.4 mg/mL and 10 mg/mL peptide solutions of the test peptides were placed. Furthermore, the discs were incorporated into the sterile plates. As a positive control, a corresponding antibiotic was used. For a negative control, a 10% ethanol solution in water was used. The studies were performed in triplicate for each concentration level and the diameter of inhibition zones (IZ) in mm was representative of the average value of the three obtained values. The standard deviation (SD) was also calculated and presented. The results attained are presented in Table 4 for the concentration of 1.4 mg/mL and Table 5 for the concentration of 10 mg/mL. The formed zones around the tested peptides appeared to be about 3-times less compared to the control antibiotics according to Table 4. The yeast strain did not show any sensitivity to the investigated samples. All obtained zones can be seen in the figures presented in Table 6.
Table 4.
Inhibition zones in mm for concentration level 1.4 mg/mL for all targeted peptides and refereed antibiotics.
Table 5.
Inhibition zones in mm for concentration level 10 mg/mL.
Table 6.
Antimicrobial test results obtained by disk-diffusion method.
For each synthesized analog and the parent peptides, the percent inhibition was calculated for B. subtilis 3562, A. oxydans 9333, and P. aeruginosa 3700 in both concentration levels, where the inhibition zone of the antibiotic was taken as a 100 percent inhibition, and from there the percent for each peptide analog was extrapolated. The values are summarized in Table 7.
Table 7.
Inhibition effect of peptide analogs against test microorganisms [%].
3.4.2. Minimal Inhibitory Concentration
In order to determine the minimum inhibitory concentrations of the tested samples, the following analyses were performed. The microbial cultures were added to the 96-well plates with peptide solutions with concentrations of 0 to 320 µg/mL. The plates were then incubated for 24 h and the absorbance was measured at 630 nm. The studies were triplicates. The obtained MIC values are summarized in Table 8.
Table 8.
MIC values of Temporin A and novel analogs [µg/mL].
Bactericidal activity was determined for B. subtilis 3562, A. oxydans 9333, and P. aeruginosa 3700. The parent peptide had MBC values of 320 µg/mL for B. subtilis 3562 and P. aeruginosa 3700.
4. Discussion
A standard SPPS using Fmoc/Ot-Bu strategy on Fmoc-Rink-amide MBHA solid phase carrier was employed for the synthesis of targeted Temporins A and F, as well as their analogs containing unnatural amino acids Orn, Dab, Dap, and Cit. Concerning the newly synthesized Temporin analogs containing unnatural amino acids, herein, the aim of this study was to investigate the role of the basicity of the amino acid in the 7th position of the molecule on both the antiproliferative and antimicrobial activities.
Taking into account the results obtained from the disk-diffusion method, the newly synthesized analogs, except the one containing non-basic Cit residue in the lateral chain (DTCit), exhibited the same tendency in bacterial activity as those reported by Rommero et al. [13]. Thus, the newly synthesized Orn-, Dab-, and Dap-containing analogs were more active towards Gram-positive bacteria. However, the removal of a positive charge in the lateral chain of Cit led to a full loss of activity. According to Rosenfeld et al. and Mangoni and Shai, a possible reason for the inactivity of Temporin A towards Gram-negative bacteria is due to the fact that the peptide oligomerizes when it comes into contact with the lipopolysaccharides and the outer membrane of the cell [14,19].
Considering the data obtained for MIC, it can be seen that the lowest MIC for all strains was at 80 µg/mL. The peptides showed lower MIC values against the Gram-positive bacteria B. subtilis 3562 and A. oxydans 9333, which fully correlates with the data obtained by Capparelli et al. [20].
However, according to the literature data reported by Paduszynska et al., Temporin A showed activity against Gram-negative P. aeruginosa. In our study, Temporin A had better activity against the chosen test strain P. aeruginosa 3700 (MIC at 320 µg/mL), whereas in the investigation of Paduszynska et al., MIC against Pseudomonas aeruginosa ATCC 9029 was determined at 512 mg/L [21].
The parent peptide DTA and the analog with Lys (DTF) showed the same behavior, i.e., being more active against the Gram(+) bacteria B. subtilis 3562 and A. oxydans 9333, and with the increase in the peptide concentration, the inhibition capacity increased. However, DTF appeared to have a slightly better antibacterial activity, which was reflected in the increased inhibition zones. Thus, the replacement of Arg with less basic Lys residue was positive for the antibacterial activity.
The highest antimicrobial potential of all analogs was revealed in DTDab. Taking into account the data obtained for the antibacterial activity of all analogs, it is clear that the shortening of the side chain had a beneficial effect on the antibacterial activity up to two methylene groups length in the lateral chain. Furthermore, shortening of the lateral chain led to a lack of a better antimicrobial effect. DTDap analog had no activity at low concentrations towards A. oxydans 9333 and P. aeruginosa 3700 but exhibited inhibition at higher values. However, it is interesting to mention that, concerning the other Gram(+) bacteria B. subtilis 3562 when using the disk-diffusion method, the same analog did not show any activity, but it had a MIC value of 320 µg/mL.
The other Gram-negative bacteria E. coli 8785 was resistant to treatment with all newly synthesized analogs and no inhibition zone was formed when using the disk-diffusion method. However, herein, the MIC values for DTA, DTF, and DTDab were also monitored. This could be explained due to the differences between the two used methods for antibacterial activity monitoring. According to Mercer et al., Kunin and Edmondson, and Lehrer et al., when positively charged AMP interacts with the negatively charged constituents of the agar, disk-diffusion methods either significantly underestimate the activity or completely mask the real activity [22,23,24]. The same phenomenon was observed with the analog DTCit and the Gram(+) bacteria A. oxydans 9333. The analog DTOrn had a bactericidal effect at 320 µg/mL against B. subtilis 3562 and at 160 µg/mL against A. oxydans 9333. DTCit also had a MBC value of 160 µg/mL against A. oxydans 9333.
When looking over the obtained MIC values and taking into consideration the differences in the six amino acids, it could be concluded that a bulkier, longer, and thus more basic side chain is needed at position 7 in order to have a lower MIC value. A shorter and less basic amino acid such as Dab delivers greater inhibition zones. Furthermore, the removal of the positive charge in the lateral chain leads to a loss of the antibacterial properties evident with the analog DTCit.
The parent peptide DTA and the previously reported DTF had antifungal activity against C. albicans 74, corresponding to the findings of Wade et al. [15]. The higher basicity of Arg and Lys proved to be vital for the antifungal potential of the temporin analogs.
Literature data indicated that temporins are toxic to normal mammalian cells within IC50 concentrations of 50 μM to 100 μM [25,26]. This is a significantly higher concentration than the concentrations at which antibacterial activity is observed [27,28]. However, methods and possibilities are being sought to modify temporins in order to increase their safety. Four of the investigated peptide analogues of Temporin A (DTCit, DTOrn, DTDab, and DTDap) showed significantly lower cytotoxicity than the original peptide (DTA). Furthermore, the photosafety test showed that the investigated peptide analogs were not phototoxic. These results show that the indicated peptides have the potential to be used safely for topical and systemic applications.
An antiproliferative activity test was performed on human cell lines, an in vitro model of healthy tissue and two types of breast cancer. The original peptide (DTA) and that substituted in the seventh position with Lys peptide (DTP) caused the highest antiproliferative effect in the cell line MCF-7 (luminal type A breast cancer). We also observed selectivity (SI > 2) with the Citrulline-substituted peptide (DTCit). In contrast, the investigated peptide analogs did not show selectivity (SI < 2) against basal type B breast cancer (MDA-MB-231 cell line). These results support the literature data on the antitumor activity of positively charged temporins and their analogues [29,30], where the authors studied different types of tumor cell lines (A549, MCF-7, MDA-MB-231). A panel of different types tumor cell lines could also be tested for more information about their antiproliferative properties.
The investigated peptide analogues had a lower antiproliferative effect compared to Temporin A (DTA), except for DTF which had an IC50 = 100.48 ± 3.30 µM for the MCF-12F cell line. The lowest antiproliferative effect against all tested cell lines combined with the lowest cito- and phototoxicity was observed after treatment with the peptide analog DTDap, the analog containing the shortest side chain and with the lowest basicity. The MCF-7 cell line was significantly more sensitive to the studied series of peptide analogs than MDA-MB-231. In MCF-7 cells, the highest antiproliferative effect was caused by the parent peptides DTF and DTA, with IC50 = 49.75 ± 1.90 µM and 73.15 ± 3.36 µM, respectively. Significant selectivity (SI > 2) was observed for the peptides DTF and the analog containing unnatural amino acid Cit (DTCit) in the MCF-7 cell line. The same analog containing a non-basic lateral chain had a relatively low cytotoxicity and a lack of phototoxicity. In contrast, the investigated peptide analogs were not sufficiently selective against triple-negative basal type B breast cancer (MDA-MB-231). Thus, the obtained results reveal that decreasing the basicity of the lateral chain from DTA through DTF and DTCit led to better selectivity according to the MCF-7 cell line. However, in the same direction, decreasing the basicity of the lateral chain of the temporin analogs led to a reduction in their antiproliferative effect. These results strongly correlate with the data obtained by Zou et al. for AMP defensins [31].
5. Conclusions
This study was dedicated to an SAR study of the role of the basicity of amino acid Arg in the position 7 of Temporin A molecule in antimicrobial activity. The obtained results reveal the following:
- -
- The Lys residue contained in the Temporin F molecule was the optimal residue for the combination of both antibacterial and antiproliferative activity;
- -
- The optimal lateral chain length for antibacterial activity was found to be two methylene groups in the molecule of Dab residue;
- -
- A bulkier, longer, and thus more basic side chain is needed at position 7 in order to have a lower MIC value, whereas a shorter and less basic amino acid such as Dab delivered greater inhibition zones when using the disk-diffusion method;
- -
- The removal of positive charge in the lateral chain led to a loss of the antibacterial properties evident with the analog DTCit. However, this analog showed satisfactory antiproliferative activity combined with a relatively low cytotoxicity and lack of phototoxicity, as well as the best selectivity according to the MCF-7 cell line.
Author Contributions
Conceptualization, N.G., I.I. and D.D. (Dancho Danalev); methodology, I.I., V.N. and T.F.; validation, I.I., N.G. and D.D. (Dilyana Dimitrova); formal analysis, D.D. (Dilyana Dimitrova), I.I., V.N. and T.F.; investigation, D.D. (Dilyana Dimitrova), I.I., V.N. and T.F.; resources, all authors; data curation, all authors; writing—original draft preparation, all authors; writing—review and editing, D.D. (Dilyana Dimitrova), I.I., D.D. (Dancho Danalev) and N.G.; visualization, D.D. (Dilyana Dimitrova), I.I., V.N. and T.F.; supervision, D.D. (Dancho Danalev), N.G., I.I., V.N. and T.F.; project administration, D.D. (Dancho Danalev); funding acquisition, all authors. All authors have read and agreed to the published version of the manuscript.
Funding
This study was supported by the European Union-NextGenerationEU, through the National Recovery and Resilience Plan of the Republic of Bulgaria, project No. BG-RRP-2.004-0002, “BiOrgaMCT”.
Institutional Review Board Statement
Not applicable.
Informed Consent Statement
Not applicable.
Data Availability Statement
Small quantities of all substances are available from authors from the University of Chemical Technology and Metallurgy.
Acknowledgments
The authors would like to thank GlobalTest Ltd. for HPLC-MS/MS analysis and the National Bank for Industrial Microorganisms and Cell Cultures (NBIMCC, Bulgaria) for test strain microorganisms.
Conflicts of Interest
The authors declare no conflicts of interest.
References
- Durand, G.A.; Raoult, D.; Dubourg, G. Antibiotic Discovery: History, Methods and Perspectives. Int. J. Antimicrob. Agents 2019, 53, 371–382. [Google Scholar] [CrossRef]
- Erdem Büyükkiraz, M.; Kesmen, Z. Antimicrobial Peptides (AMPs): A Promising Class of Antimicrobial Compounds. J. Appl. Microbiol. 2022, 132, 1573–1596. [Google Scholar] [CrossRef]
- Murray, C.J.L.; Ikuta, K.S.; Sharara, F.; Swetschinski, L.; Robles Aguilar, G.; Gray, A.; Han, C.; Bisignano, C.; Rao, P.; Wool, E.; et al. Global Burden of Bacterial Antimicrobial Resistance in 2019: A Systematic Analysis. Lancet 2022, 399, 629–655. [Google Scholar] [CrossRef]
- Kang, H.-K.; Kim, C.; Seo, C.H.; Park, Y. The Therapeutic Applications of Antimicrobial Peptides (AMPs): A Patent Review. J. Microbiol. 2017, 55, 1–12. [Google Scholar] [CrossRef] [PubMed]
- Lei, J.; Sun, L.; Huang, S.; Zhu, C.; Li, P.; He, J.; Mackey, V.; Coy, D.H.; He, Q. The Antimicrobial Peptides and Their Potential Clinical Applications. Am. J. Transl. Res. 2019, 11, 3919. [Google Scholar]
- Pushpanathan, M.; Gunasekaran, P.; Rajendhran, J. Antimicrobial Peptides: Versatile Biological Properties. Int. J. Pept. 2013, 2013, 675391. [Google Scholar] [CrossRef]
- Felício, M.R.; Silva, O.N.; Gonçalves, S.; Santos, N.C.; Franco, O.L. Peptides with Dual Antimicrobial and Anticancer Activities. Front. Chem. 2017, 5, 5. [Google Scholar] [CrossRef] [PubMed]
- Huan, Y.; Kong, Q.; Mou, H.; Yi, H. Antimicrobial Peptides: Classification, Design, Application and Research Progress in Multiple Fields. Front. Microbiol. 2020, 11, 582779. [Google Scholar] [CrossRef] [PubMed]
- Vladkova, T.G.; Martinov, B.L.; Gospodinova, D.N. Anti-Biofilm Agents from Marine Biota. JCTM 2023, 58, 825–839. [Google Scholar] [CrossRef]
- Zasloff, M. Magainins, a Class of Antimicrobial Peptides from Xenopus Skin: Isolation, Characterization of Two Active Forms, and Partial cDNA Sequence of a Precursor. Proc. Natl. Acad. Sci. USA 1987, 84, 5449–5453. [Google Scholar] [CrossRef]
- Xuan, J.; Feng, W.; Wang, J.; Wang, R.; Zhang, B.; Bo, L.; Chen, Z.-S.; Yang, H.; Sun, L. Antimicrobial Peptides for Combating Drug-Resistant Bacterial Infections. Drug Resist. Updates 2023, 68, 100954. [Google Scholar] [CrossRef] [PubMed]
- Simmaco, M.; Mignogna, G.; Canofeni, S.; Miele, R.; Mangoni, M.L.; Barra, D. Temporins, Antimicrobial Peptides from the European Red Frog Rana temporaria. Eur. J. Biochem. 1996, 242, 788–792. [Google Scholar] [CrossRef] [PubMed]
- Romero, S.M.; Cardillo, A.B.; Martínez Ceron, M.C.; Camperi, S.A.; Giudicessi, S.L. Temporins: An Approach of Potential Pharmaceutic Candidates. Surg. Infect. 2020, 21, 309–322. [Google Scholar] [CrossRef] [PubMed]
- Rosenfeld, Y.; Barra, D.; Simmaco, M.; Shai, Y.; Mangoni, M.L. A Synergism between Temporins toward Gram-Negative Bacteria Overcomes Resistance Imposed by the Lipopolysaccharide Protective Layer. J. Biol. Chem. 2006, 281, 28565–28574. [Google Scholar] [CrossRef] [PubMed]
- Wade, D.; Silberring, J.; Soliymani, R.; Heikkinen, S.; Kilpeläinen, I.; Lankinen, H.; Kuusela, P. Antibacterial Activities of Temporin A Analogs. FEBS Lett. 2000, 479, 6–9. [Google Scholar] [CrossRef] [PubMed]
- Deslouches, B.; Di, Y.P. Antimicrobial Peptides with Selective Antitumor Mechanisms: Prospect for Anticancer Applications. Oncotarget 2017, 8, 46635–46651. [Google Scholar] [CrossRef] [PubMed]
- Schweizer, F. Cationic Amphiphilic Peptides with Cancer-Selective Toxicity. Eur. J. Pharmacol. 2009, 625, 190–194. [Google Scholar] [CrossRef] [PubMed]
- Mosmann, T. Rapid Colorimetric Assay for Cellular Growth and Survival: Application to Proliferation and Cytotoxicity Assays. J. Immunol. Methods 1983, 65, 55–63. [Google Scholar] [CrossRef] [PubMed]
- Mangoni, M.L.; Shai, Y. Temporins and Their Synergism against Gram-Negative Bacteria and in Lipopolysaccharide Detoxification. Biochim. Biophys. Acta (BBA)—Biomembr. 2009, 1788, 1610–1619. [Google Scholar] [CrossRef]
- Capparelli, R.; Romanelli, A.; Iannaccone, M.; Nocerino, N.; Ripa, R.; Pensato, S.; Pedone, C.; Iannelli, D. Synergistic Antibacterial and Anti-Inflammatory Activity of Temporin A and Modified Temporin B In Vivo. PLoS ONE 2009, 4, e7191. [Google Scholar] [CrossRef]
- Paduszynska, M.A.; Greber, K.E.; Paduszynski, W.; Sawicki, W.; Kamysz, W. Activity of Temporin A and Short Lipopeptides Combined with Gentamicin against Biofilm Formed by Staphylococcus Aureus and Pseudomonas Aeruginosa. Antibiotics 2020, 9, 566. [Google Scholar] [CrossRef]
- Mercer, D.K.; Torres, M.D.T.; Duay, S.S.; Lovie, E.; Simpson, L.; Von Köckritz-Blickwede, M.; De La Fuente-Nunez, C.; O’Neil, D.A.; Angeles-Boza, A.M. Antimicrobial Susceptibility Testing of Antimicrobial Peptides to Better Predict Efficacy. Front. Cell. Infect. Microbiol. 2020, 10, 326. [Google Scholar] [CrossRef]
- Kunin, C.M.; Edmondson, W.P. Inhibitor of Antibiotics in Bacteriologic Agar. Exp. Biol. Med. 1968, 129, 118–122. [Google Scholar] [CrossRef]
- Lehrer, R.I.; Rosenman, M.; Harwig, S.S.S.L.; Jackson, R.; Eisenhauer, P. Ultrasensitive Assays for Endogenous Antimicrobial Polypeptides. J. Immunol. Methods 1991, 137, 167–173. [Google Scholar] [CrossRef]
- Mäntylä, T.; Sirola, H.; Kansanen, E.; Korjamo, T.; Lankinen, H.; Lappalainen, K.; Välimaa, A.L.; Harvima, I.; Närvänen, A. Effect of Temporin A Modifications on Its Cytotoxicity and Antimicrobial Activity. APMIS 2005, 113, 497–505. [Google Scholar] [CrossRef]
- Rinaldi, A.C.; Mangoni, M.L.; Rufo, A.; Luzi, C.; Barra, D.; Zhao, H.; Kinnunen, P.K.J.; Bozzi, A.; Giulio, A.D.; Simmaco, M. Temporin L: Antimicrobial, Haemolytic and Cytotoxic Activities, and Effects on Membrane Permeabilization in Lipid Vesicles. Biochem. J. 2002, 368, 91–100. [Google Scholar] [CrossRef]
- Harjunpää, I.; Kuusela, P.; Smoluch, M.T.; Silberring, J.; Lankinen, H.; Wade, D. Comparison of Synthesis and Antibacterial Activity of Temporin A. FEBS Lett. 1999, 449, 187–190. [Google Scholar] [CrossRef]
- Tan, X.; Xie, S.; Jin, X.; Zhu, R.; Wei, S.; Song, Y.; Xie, X.; Wang, R.; Li, L.; Wang, M.; et al. Four Temporin-Derived Peptides Exhibit Antimicrobial and Antibiofilm Activities against Methicillin-Resistant Staphylococcus aureus. ABBS 2022, 54, 350–360. [Google Scholar] [CrossRef]
- Swithenbank, L.; Cox, P.; Harris, L.G.; Dudley, E.; Sinclair, K.; Lewis, P.; Cappiello, F.; Morgan, C. Temporin A and Bombinin H2 Antimicrobial Peptides Exhibit Selective Cytotoxicity to Lung Cancer Cells. Scientifica 2020, 2020, 3526286. [Google Scholar] [CrossRef]
- Wang, C.; Tian, L.-L.; Li, S.; Li, H.-B.; Zhou, Y.; Wang, H.; Yang, Q.-Z.; Ma, L.-J.; Shang, D.-J. Rapid Cytotoxicity of Antimicrobial Peptide Tempoprin-1CEa in Breast Cancer Cells through Membrane Destruction and Intracellular Calcium Mechanism. PLoS ONE 2013, 8, e60462. [Google Scholar] [CrossRef]
- Zou, G.; De Leeuw, E.; Li, C.; Pazgier, M.; Li, C.; Zeng, P.; Lu, W.-Y.; Lubkowski, J.; Lu, W. Toward Understanding the Cationicity of Defensins. J. Biol. Chem. 2007, 282, 19653–19665. [Google Scholar] [CrossRef] [PubMed]
Disclaimer/Publisher’s Note: The statements, opinions and data contained in all publications are solely those of the individual author(s) and contributor(s) and not of MDPI and/or the editor(s). MDPI and/or the editor(s) disclaim responsibility for any injury to people or property resulting from any ideas, methods, instructions or products referred to in the content. |
© 2024 by the authors. Licensee MDPI, Basel, Switzerland. This article is an open access article distributed under the terms and conditions of the Creative Commons Attribution (CC BY) license (https://creativecommons.org/licenses/by/4.0/).